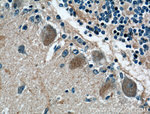
MTMR2 Antibody in Immunohistochemistry (Paraffin) (IHC (P))

Search
Proteintech
MTMR2 Polyclonal Antibody
{{$productOrderCtrl.translations['antibody.pdp.commerceCard.promotion.promotions']}}
{{$productOrderCtrl.translations['antibody.pdp.commerceCard.promotion.viewpromo']}}
{{$productOrderCtrl.translations['antibody.pdp.commerceCard.promotion.promocode']}}: {{promo.promoCode}} {{promo.promoTitle}} {{promo.promoDescription}}. {{$productOrderCtrl.translations['antibody.pdp.commerceCard.promotion.learnmore']}}
产品信息
14372-1-AP
种属反应
宿主/亚型
分类
类型
抗原
偶联物
形式
浓度
规格
纯化类型
保存液
内含物
保存条件
运输条件
产品详细信息
Immunogen sequence: KRSKEDEKY LQAIMDSNAQ SHKIFIFDAR PSVNAVANKA KGGGYESEDA YQNAELVFLD IHNIHVMRES LRKLKEIVYP NIEETHWLSN LESTHWLEHI KLILAGALRI ADKVESGKTS VVVHCSDGWD RTAQLTSLAM LMLDGYYRTI RGFEVLVEKE WLSFGHRFQL RVGHGDKNHA DADRSPVFLQ FIDCVWQMTR QFPTAFEFNE YFLITILDHL YSCLFGTFLC NSEQQRGKEN LPKRTVSLWS YINSQLEDFT NPLYGSYSNH VLYPVASMRH LELWVGYYIR WNPRMKPQEP IHNRYKELLA KRAELQKKVE ELQREISNRS TSSSERASSP AQCVTPVQTV V (294-643 aa encoded by BC052990)
靶标信息
This gene is a member of the myotubularin family. The encoded protein possesses phosphatase activity towards phosphatidylinositol-3-phosphate and phosphatidylinositol-3,5-bisphosphate. Mutations in this gene are a cause of Charcot-Marie-Tooth disease type 4B, an autosomal recessive demyelinating neuropathy. Multiple alternatively spliced transcript variants have been found for this gene.
仅用于科研。不用于诊断过程。未经明确授权不得转售。
篇参考文献 (0)
生物信息学
蛋白别名: Myotubularin-related protein 2; phosphatidylinositol-3,5-bisphosphate 3-phosphatase; Phosphatidylinositol-3,5-bisphosphate 3-phosphatase MTMR2; phosphatidylinositol-3-phosphatase; Phosphatidylinositol-3-phosphate phosphatase; phosphoinositide-3-phosphatase; unnamed protein product
基因别名: 6030445P13Rik; CMT4B; CMT4B1; KIAA1073; MTMR2
UniProt ID: (Human) Q13614, (Mouse) Q9Z2D1
Entrez Gene ID: (Human) 8898, (Mouse) 77116, (Rat) 315422